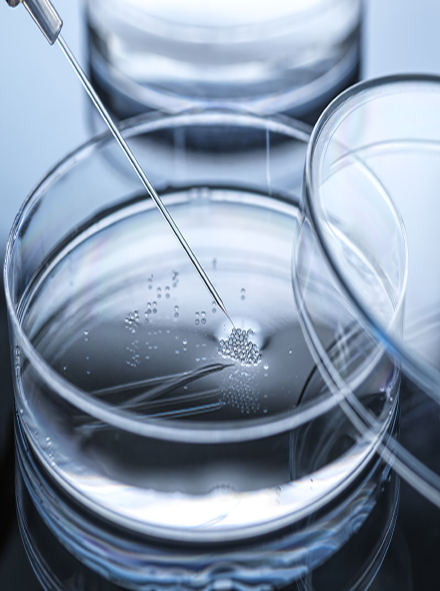
A Study on Improving the Designation Criteria and Post-Management for Embryo-Producing Medical Institutions

PRESS RELEASE
KIHASA and GIST Forge Partnership in Research and Industry-Academia Cooperation
KIHASA signed a Memorandum of Understanding (MoU) with the Gwangju Institute of Science and Technology on Friday, January 16, at the main conference room of GIST’s Administrative Building. The MoU aims to promote mutual exchange and industry-academia cooperation in the fields of health and welfare.
Publications
Reports
1/2
Research in Brief
Periodicals
1/3